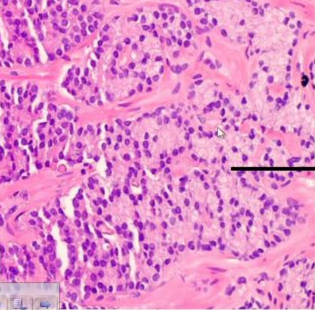

Eosinophilic Amorphous secretions (an intraluminal feature of prostate carcinoma)

Collagenous Micronodules (pathognomonic feature of PCa)

Corpora Amylacea, strongly suggests benign

Crystalline Eosinophilic, Intraluminal feature present in 41% of PCa
What Gleason Grade?

Grade 2
What Gleason Grade?

Grade 3
What Gleason Grade?
Grade 4
What Gleason Grade?

Grade 5

Intraluminal Blue Mucin - an intraluminal feature of PCa

Normal prostate

Perineural circumferential involvement, pathognomonic of PCa
What grade is this?

Grade 1